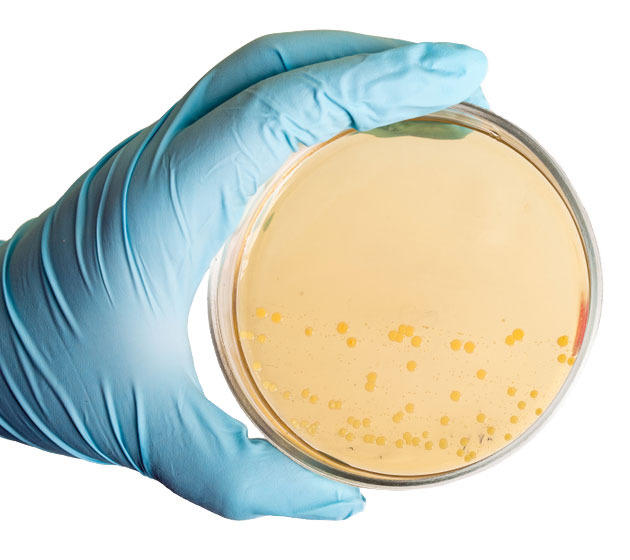
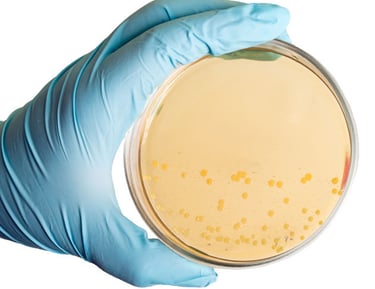

Quality Sulphur Products for Agriculture
Welcome to Agrowin Agri Solution Pvt. Ltd.
Welcome to Agrowin Agri Solution Pvt. Ltd., a leading name in the agricultural sector, specializing in the manufacturing and supplying of Sulphur 80% WDG (Water Dispersible Granules) across India. With a commitment to enhancing agricultural productivity and sustainability, we provide high-quality products that meet the diverse needs of farmers and agricultural professionals. Our state-of-the-art manufacturing processes ensure the highest standards of purity and efficacy, making our Sulphur 80% WDG an essential component for effective crop protection and soil health.
At Agrowin, we believe in empowering farmers with innovative solutions that foster growth, resilience, and environmental stewardship. Join us in cultivating a greener, more productive future for agriculture in India.



Sustainability and Innovation


Sulfur plays a crucial role in shaping the future of several industries, particularly in agriculture, energy, and technology. As the world grapples with the challenges of food security and sustainable agriculture, sulfur's role as an essential nutrient for plant growth becomes more important. It is key in producing sulfur-based fertilizers that enhance crop yield, especially in sulfur-deficient soils, which are increasingly common in industrialized farming.
Additionally, sulfur is critical in renewable energy technologies, such as the development of hydrogen energy. Sulfur compounds, like hydrogen sulfide, are being explored as part of sustainable energy systems, potentially enabling cleaner energy solutions. In the realm of technology, sulfur-based materials are being investigated for use in advanced batteries for electric vehicles and energy storage, offering a more abundant and eco-friendly alternative to lithium. As such, sulfur is positioned to be a pivotal element in driving future innovations for a more sustainable and efficient world.





Commitment to Quality
At Agrowin Agri Solution Pvt. Ltd., our commitment to quality is at the core of everything we do. We understand that the success of our farmers depends on the reliability and effectiveness of our products. That’s why we adhere to stringent quality control measures throughout the manufacturing process of our Sulphur 80% WDG.
Our advanced facilities utilize the latest technology and best practices to ensure that each batch meets the highest industry standards. We source only premium raw materials, and our dedicated team of experts conducts rigorous testing to guarantee product purity and performance.
By prioritizing quality, we aim to deliver solutions that not only enhance crop yields but also promote sustainable agricultural practices, supporting the long-term health of our planet.
Quality Sulphur Products
Agrowin provides high-quality Sulphur Products for Agriculture and Industry, enhancing productivity and sustainability.
High Purity Level


Manufactured Sulphur 80% WDG is characterized by its high purity level, ensuring effective performance in pest control and soil health enhancement without harmful impurities that could affect crop quality.

Consistent Particle Size
The product features a uniform particle size, which promotes even dispersion in water and consistent application, leading to more effective absorption by plants and optimal results.
Sulphur 80% WDG is formulated for stability, allowing it to maintain its efficacy over time and under various storage conditions, ensuring that farmers receive a reliable product that performs well when needed.
Stability & Shelf Life

Contact Us
Get in touch for quality sulphur products and support.
Agrowin Agri Solution Pvt. Ltd. is a leading manufacturer and supplier of Sulphur 80% WDG in India, committed to enhancing agricultural productivity and sustainability. With state-of-the-art facilities and rigorous quality control, we ensure that our products meet the highest industry standards ... Read more
Contact Us
Email Subscription
Gram-Malti, Post-Pipra Dewas
Near Jio Pump, Distt - Begusarai
Bihar - 851101 India
Phone : +91 98522 86761
Email : sulphur@agrowingroup.com
Agrowin Agri Solution Pvt. Ltd.
© 2024-26 by Agrowin Agri Solution Pvt. Ltd.
Navigation
All Rights Reserved.
